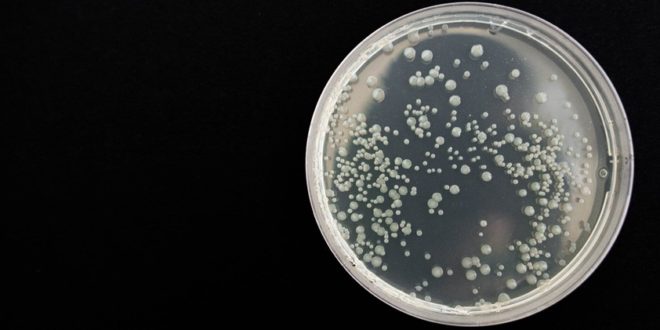

Studie zveřejněná v časopise Nature Communications představuje zásadní posun v mikrobiologii: vědcům se podařilo poprvé přenést do kultury rozsáhlou kolekci sladkovodních bakterií, které se dosud nedařilo kultivovat. Přestože jsou tyto organismy v přírodě velmi rozšířené, ve veřejných sbírkách kmenů se objevují jen výjimečně.
Až dosud se většina pokusů o pěstování mikrobů soustředila na rychle rostoucí druhy, kterým se daří v živinami bohatých médiích. Mnohé z nejhojnějších vodních bakterií však rostou pomalu a jsou přizpůsobeny prostředí s nízkým obsahem živin – právě proto se je dlouho nedařilo v laboratoři kultivovat. Nový výzkum vedený vědci z Biologického centra AV ČR tuto mezeru překlenul: podařilo se jim vypěstovat 627 čistých kmenů bakterií ze 72 rodů pocházejících ze 14 středoevropských jezer.
Kultivace „nekultivovatelných“
Mezinárodní tým vedený Michaelou Salcher, vedoucí Laboratoře kultivace mikrobů a ekogenomiky v Českých Budějovicích, využil speciální metodu zvanou „dilution-to-extinction“. Ta spočívá v postupném ředění vzorků a kombinovala se s kultivačními médii, která napodobují přírodní jezerní vodu s nízkým obsahem živin. Takto připravené podmínky umožnily růst pomalu rostoucím druhům a zároveň zabránily jejich přerůstání rychlejšími konkurenty.
Díky této metodě získali vědci kultury mnoha hojně rozšířených bakterií, včetně 15 z 30 nejběžnějších rodů sladkovodních mikrobů. Tyto bakterie představují významnou část společenstev ve sladkých vodách celého světa.
Nově založená sbírka zahrnuje i řadu dosud nekultivovaných kmenů ze známých skupin, jako jsou Actinomycetota, Pseudomonadota, Verrucomicrobiota a Bacteroidota, a vůbec prvního volně žijícího sladkovodního zástupce kmene Armatimonadota. Mezi kultivovanými kmeny jsou také zástupci velmi hojných rodů, například Fontibacterium (přezdívané „sladkovodní SAR11“), Methylopumilus či Planktophila. Tyto bakterie dosud ve sbírkách chyběly, protože rostou pomalu nebo vyžadují speciální podmínky. Nově vzniklá sbírka tedy významně rozšiřuje přístup k těmto dříve nedostupným liniím.
Od jezer k celosvětovému kontextu
Metagenomické sekvenování vzorků ukázalo, že čerstvě kultivované kmeny tvoří podstatnou část mikrobiálních společenstev v jezerech. Analýza více než 460 veřejně dostupných sladkovodních metagenomů ze šesti kontinentů navíc potvrdila, že mnoho z těchto bakterií je rozšířeno po celém světě.
Nové objevy v oblasti mikrobiální rozmanitosti a metabolismu
Sekvenování genomů 87 kmenů odhalilo dvě nové čeledi, devět nových rodů a 41 nových druhů bakterií. Výsledky ukázaly i různé ekologické strategie, jak se mikrobi přizpůsobují prostředí, například:
„Zeštíhlování“ genomu: některé druhy (např. Fontibacterium, Planktophila) mají malé genomy, které jsou energeticky úsporné, ale méně flexibilní. To je výhodné v prostředí s nedostatkem živin.
Využívání světla: mnoho kmenů dokáže získávat energii ze světla různými způsoby. Některé dokonce nesou geny pro enzym RuBisCO, který umožňuje fixaci uhlíku podobně jako u rostlin.
Metabolismus síry a dusíku či sdílení vitaminů: byly popsány rozmanité metabolické dráhy týkající se metabolismu síry a dusíku či zahrnující biosyntézu vitaminů. Většina kmenů nedokáže sama vyrábět některé vitaminy, například B₁₂, a spoléhá na ostatní členy společenstva. Jiné kmeny naopak vitaminy produkují a uvolňují je do prostředí.
Tato vzájemná provázanost ukazuje, jak složité vztahy mezi mikroorganismy ve vodním prostředí mohou být.
Proč je to důležité
Nově kultivované bakterie vyplňují zásadní mezeru ve výzkumu mikrobů: umožňují studovat hojné a ekologicky významné organismy, které byly dosud pro vědce „nedostupné“. Díky nim lze v kontrolovaných podmínkách zkoumat základních ekologické a evoluční otázky, například: Jak spolu tito mikrobi interagují? Co omezuje jejich růst? Jak tyto mikroorganismy může ovlivnit změna prostředí?
Nová sbírka kmenů a jejich genomy jsou veřejně dostupné. Stávají se tak klíčovým zdrojem informací pro studium role mikroorganismů v koloběhu uhlíku a živin, kvalitě vody, odolnosti ekosystémů a v mnoha dalších oblastech.
Salcher MM, Layoun P, Fernandes C, Chiriac M-C, Bulzu P-A, Ghai R, Shabarova T, Lanta V, Callieri C, Sonntag B, Posch T, Lepori F, Znachor P, Haber M (2025) Bringing the uncultivated microbial majority of freshwater ecosystems into culture. Nature Communications 16:7971. DOI: 10.1038/s41467-025-63266-9
 Sciencemag.cz
Sciencemag.cz